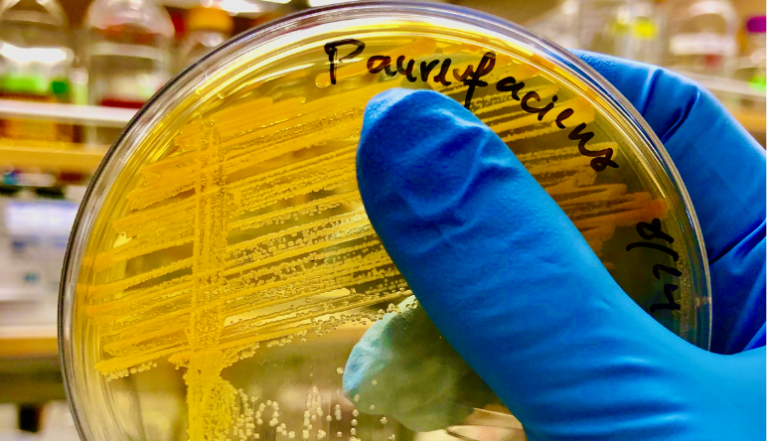
A glove hand holding a petri dish with Soil bacteria like Pseudomonas

Our Research Using secondary metabolites to manage legacy phosphorus

Phosphorus is an essential nutrient that often has low bioavailability in soils. Credit – Darcy McRose

The model plant Arabidopsis (shown here) makes secondary metabolites that may help solubilize phosphorus. Credit – Darcy McRose
Soil bacteria like Pseudomonas (pictured here) may be able to make plant metabolites more effective at phosphorus solubilization. Credit – Darcy McRose

The phosphorus-solubilizing metabolites made by Arabidopsis are also thought to be made by many food crops. Credit – Darcy McRose
Principal Investigator
Darcy McRose
- Thomas D. and Virginia W. Cabot Career Development Assistant Professor
- Civil and Environmental Engineering
Darcy McRose is the Thomas D. and Virginia W. Cabot Career Development Assistant Professor of Civil and Environmental Engineering. She earned a bachelor’s degree in Earth systems at Stanford and a PhD in geosciences at Princeton University. She completed postdoctoral training at Caltech in the divisions of biology and biological engineering and geological and planetary sciences. Her laboratory focuses on metabolites made by microorganisms and plants and draws on techniques from molecular biology, chemistry, and geosciences to study these molecules and their effects on soil fertility and plant growth.
Challenge:
Can plant metabolites and soil bacteria be harnessed to make phosphorus more bioavailable?
Research Strategy
- Use laboratory experiments to determine whether a combination of plant metabolites and soil bacteria can be used to make mineral-associated phosphorus more bioavailable.
- Test the efficiency of phosphorus solubilization in natural and managed soils and develop tools to image exchanges of phosphorus between plants and microbes.
Project description
The nutrient phosphorus is essential for agricultural plant growth. When added as a fertilizer, phosphorus sticks to the surface of soil minerals, decreasing bioavailability and accumulating residual phosphorus. Heavily fertilized agricultural soils often harbor large reservoirs of this type of mineral-associated “legacy” phosphorus. Redox transformations are one chemical process that can liberate mineral-associated phosphorus. However, this needs to be carefully controlled as overly mobile phosphorus can lead to runoff and pollution of natural waters. Ideally, phosphorus would be made bioavailable when plants need it and immobile when they don’t.
Many plants make small metabolites that might be able to solubilize mineral-adsorbed phosphorus and be activated and inactivated under different conditions. McRose will use laboratory experiments to determine whether a combination of plant metabolites and soil bacteria can be used as a highly efficient and tunable system for phosphorus solubilization. She also aims to develop an imaging platform to investigate exchanges of phosphorus between plants and soil microbes. This work will embolden future research into the use of microbe-metabolite systems to solubilize phosphorus.
News
Additional Details
Impact Areas
- Water
- Food
Research Themes
- Water Resources & Infrastructure
- Sustainability & Adaptation
- Soil Fertility & Crop Productivity
- Transforming Food Systems
Year Funded
- 2023
Grant Type
- Seed Grant
Status
- Ongoing

